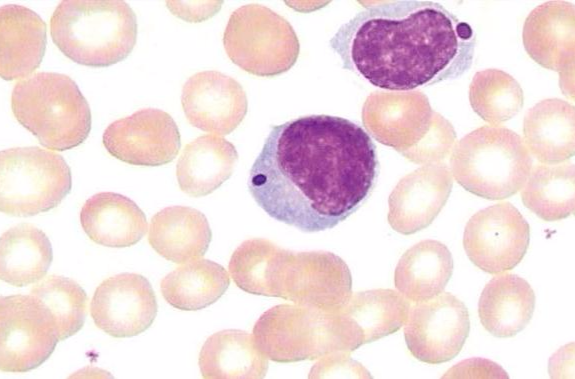
p>淋巴细胞(lymphocyte)是白细胞的一种,是体积最小的白细胞.

lymphocyte

p>淋巴细胞(lymphocyte)是白细胞的一种,是体积最小的白细胞.
图片尺寸649x434
p>淋巴细胞(lymphocyte)是白细胞的一种,是体积最小的白细胞.
图片尺寸575x379
淋巴细胞lymphocyte
图片尺寸907x443
3d model lymphocyte t-cell b-cell https://static.turbosquid.
图片尺寸1480x800
bone marrow-dependent lymphocyte
图片尺寸600x540
3d model lymphocyte t-cell b-cell
图片尺寸1480x800
3d model lymphocyte t-cell b-cell
图片尺寸1480x800
预订essential oncology of the lymphocyte
图片尺寸278x400
第九章 b淋巴细胞 lymphocyte) (bursa or bone marrow lymphocyte)
图片尺寸1080x810
3d model lymphocyte t-cell b-cell
图片尺寸1480x800
淋巴细胞分离液,lymphocyte separation media
图片尺寸541x579
淋巴细胞细胞因子
图片尺寸552x289
white blood cells lymphocyte 3d
图片尺寸600x600
免疫学讨论版 免疫学基础理论 ctla4–ig (cytotoxic t lymphocyte
图片尺寸2999x2249
role of dendritic cells in the induction of lymphocyte tolerance
图片尺寸1362x900
thymus-dependent lymphocyte
图片尺寸500x394
thymus-dependent lymphocyte
图片尺寸500x400
混合淋巴细胞反应(mixed lymphocyte
图片尺寸598x301
thymus-dependent lymphocyte
图片尺寸500x400
独特型
图片尺寸268x266